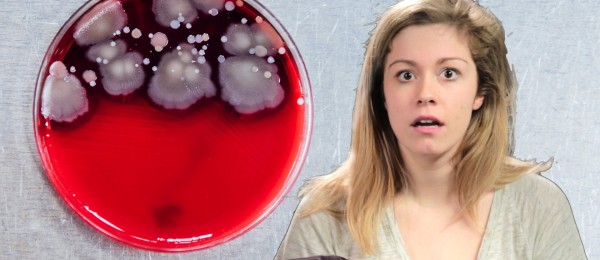

Vanhukset yrittivät arvailla slangisanojen tarkoitusta – eihän se mennyt putkeen
Nuorisolla on aina ollut oma tapansa puhua. Monesti nuorien käyttämät slangisanat menevät täysin vanhemman kansan ymmärryksen yli. Nyt eräät seniorit ovat yrittäneet arvailla nykynuorten käyttämien sanojen tarkoituksia.